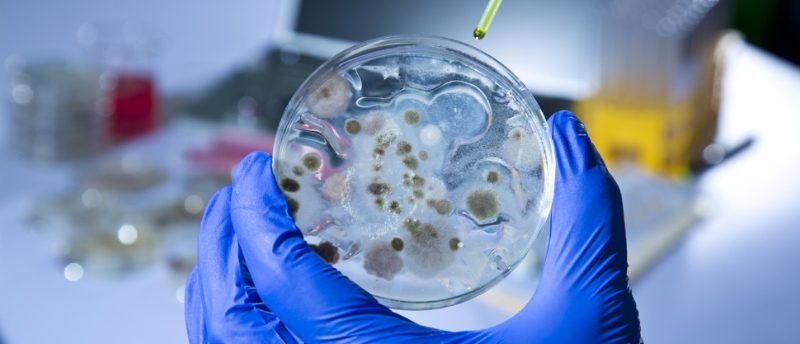

Efficient extraction of proteins from bacterial cells
SoluLyse™ from Amsbio (Oxford, UK) is a bacterial protein extraction reagent that provides a highly efficient yet gentle method for extracting soluble proteins from bacterial cells.
Based upon a proprietary non-ionic detergent formulation, with the SoluLyse™ reagent, there is no need for time-consuming and cumbersome secondary treatment methods such as sonication or freeze thaw. The unique, mild SoluLyse™ formulation allows perforation of bacterial cell walls without denaturing proteins.
In addition, the SoluLyse™ reagent offers an up to ten-fold increase in the yield of soluble proteins when compared with other commercial lysis reagents.
Treatment of bacterial cells with SoluLyse™ results in rapid and efficient extraction of proteins that are suitable for affinity purification and analysis. The SoluLyse™ reagent may also be used for the preparation of high-purity inclusion bodies from total cell lysates.
Employing a simple and quick 1-step protocol – SoluLyse™ is proven to provide superior large-scale bacterial protein extraction and high-throughput cell lysis results. A recent study published in PNAS Nexus (OUP, 2025) highlighted SoluLyse™ as an effective reagent for high-throughput membrane protein research, demonstrating its performance in demanding applications. Broad compatibility with bacterial strains such as E. coli BL21 and affinity systems (GST, His), makes SoluLyse™ a plug-in reagent for protein-expression labs.
To learn more about SoluLyse™ bacterial protein extraction reagent, please visit https://www.amsbio.com/solulyse-bacterial-protein-extraction-reagent or contact Amsbio on +31-72-8080244 / +44-1235-828200 / +1-617-945-5033 / [email protected].
About Amsbio
Now part of the Europa Biosite group of companies, AMS Biotechnology (Amsbio) is recognized as a leading transatlantic company contributing to the acceleration of discovery through the provision of cutting-edge life science technology, products and services for R&D in the medical, nutrition, cosmetics and energy industries. Amsbio has in-depth expertise in extracellular matrices (ECMs) to provide elegant solutions for studying cell motility, migration, invasion and proliferation. This expertise in cell culture and the ECM allows Amsbio to partner with clients in tailoring cell systems to enhance organoid and spheroid screening outcomes using a variety of 3D culture systems, including organ-on-a-chip microfluidics. For drug discovery research, Amsbio offers assays, recombinant proteins and cell lines. Drawing upon a huge and comprehensive biorepository, Amsbio is widely recognized as a leading provider of high-quality tissue specimens (including custom procurement) from both human and animal tissues. The company provides unique clinical-grade products for stem cells and cell therapy applications. This includes GMP cryopreservation technology and high-quality solutions for viral delivery.